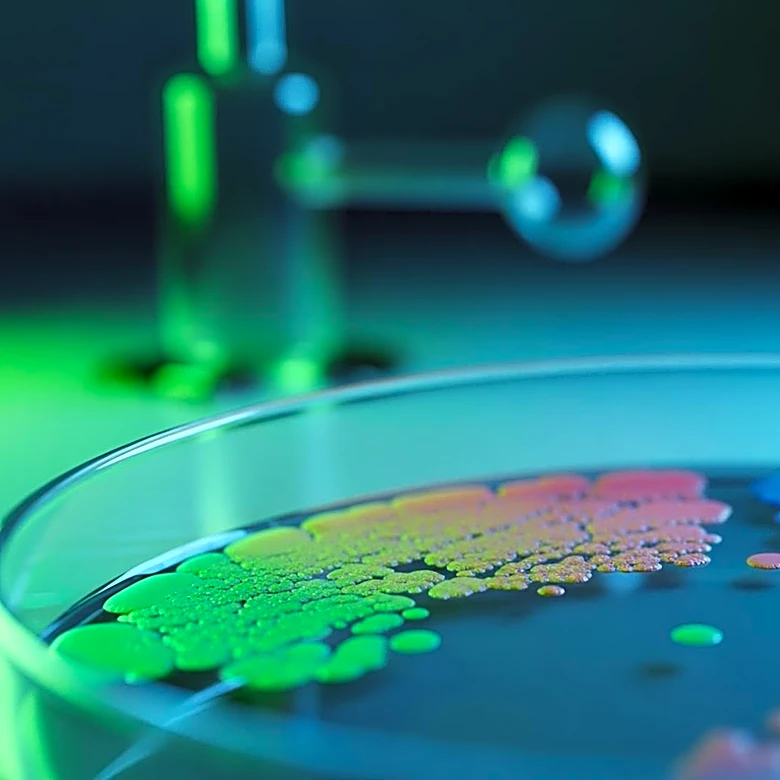
Scientists Investigate Microbiome for Rising Colorectal Cancer Rates in Young Adults

What's Happening?
Recent insights from health experts suggest that starting a new exercise routine during pregnancy is not only safe but beneficial. Shannon Ritchey, PT, DPT, emphasizes that pregnancy can be a time of strength rather than physical decline. Cynthia Gyamfi-Bannerman,
MD, highlights that exercise can decrease pregnancy complications and increase the likelihood of vaginal delivery. Research supports that physical activity during pregnancy improves overall health, reduces the risk of gestational diabetes, hypertension, and preeclampsia, and may lower the likelihood of preterm birth. Strength training, in particular, helps counteract physical changes during pregnancy, reducing aches and pains. Christina Prevett, PT, PhD, notes that active pregnant women tend to have lower C-section rates, although fitness is not a guarantee of a vaginal delivery.
Why It's Important?
The promotion of exercise during pregnancy marks a shift in traditional advice, which often discouraged new physical activities. This change is significant as it aligns with growing evidence that physical fitness can lead to better health outcomes for both mother and child. By encouraging exercise, healthcare providers aim to improve maternal health, reduce medical interventions, and enhance postpartum recovery. This approach could lead to a reduction in healthcare costs associated with pregnancy complications and improve the quality of life for expectant mothers. The emphasis on strength training also supports long-term health benefits, potentially reducing the risk of chronic conditions later in life.
What's Next?
As more healthcare providers adopt these recommendations, there may be an increase in prenatal fitness programs and resources. Expectant mothers might see more tailored exercise plans that accommodate their changing bodies and health needs. The fitness industry could respond by developing specialized prenatal workout programs and equipment. Additionally, ongoing research may continue to refine guidelines, ensuring they are inclusive of diverse populations and health conditions. Healthcare systems might also integrate exercise recommendations into standard prenatal care, emphasizing the importance of physical activity from the early stages of pregnancy.